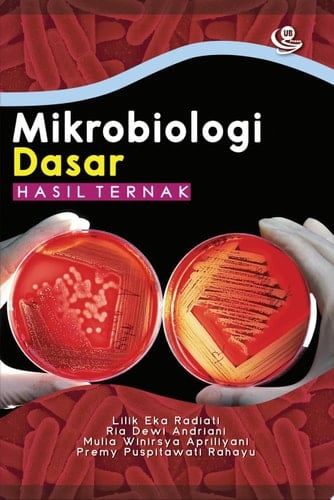
Mikrobiologi Dasar Hasil Ternak

Mikrobiologi merupakan salah satu cabang ilmu yang telah menjadi pusat perhatian yang kian berkembang karena banyak berperan dalam pemanfaatan sumber daya dan dapat digunakan sebagai bahan konsumsi manusia. Dengan adanya mikrobiologi maka produk-produk peternakan dalam bidang teknologi hasil ternak dapat dikembangkan. Mikroba dimanfaatkan untuk meningkatkan kualitas hasil ternak sehingga niliai ekonomisnya juga akan meningkat. Secara singkat dapat disampaikan bahwa ini merupakan buku ajar yang dapat digunakan sebagai pendamping bagi mahasiswa atau masyarakat luas dalam bidang mikrobiologi pengolahan hasil ternak. Buku ini lebih dititikberatkan pada knowledge (pengetahuan), sedangkan pada praktikum lebih dititikberatkan pada skill (keterampilan) mahasiswa terhadap mikrobiologi. Buku ini diterbitkan secara utuh yang menjabarkan tentang materi pembelajaran selama satu semester. Susunan buku ajar ini terdiri dari BAB I: Pendahuluan Arah dan Capaian Pembelajaran; BAB II: Pengantar Proses Perkembangan Ilmu Mikrobiologi; BAB III: Ragam Mikroba; BAB IV: Perkembangan Mikroba; BAB V: Teknik Dasar Mikrobiologi; dan BAB VI: Aplikasi Mikrobiologi dalam Industri Peternakan (Pengolahan Hasil Ternak seperti yoghurt, keju, dan kefir). Diharapkan buku Mikrobiologi Dasar Hasil Ternak ini dapat bermanfaat bagi mahasiswa, para peneliti di bidang pangan, peternakan, pertanian pada umumnya, dan olahan hasil ternak pada khususnya serta masyarakat luas terutama bagi para pengusaha untuk memberikan inspirasi dan penguatan keilmuan dalam rangka mengolah produk.
Page Count:
162
Publication Date:
2019-12-31
ISBN-10:
6024329237
ISBN-13:
9786024329235
No comments yet. Be the first to share your thoughts!